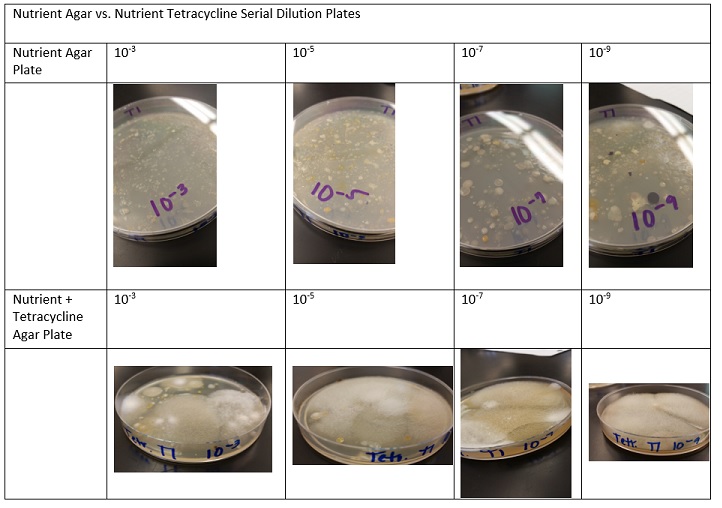

User:Emily R. Lafferman/Notebook/Biology 210 at AU
3/17/15
This most recent consisted of peer-reviewing the introductions of the zebrafish experiments. Due to the shared lab space, both the nicotine and control sample of the fish were missing - most likely spilled on the floor (and left for dead) - a very sad say indeed. However, deceased members of both groups were preserved in the previous lab, and these specimens were placed into depressions slides and analyzed under 10X magnification. It was determined from the use of the ocular micrometer that the nicotine exposed fish displayed slightly smaller eye diameter and total length than those in the control group. Although this difference only varied by a matter of 5-10 micrometers, it may indicate nicotine's slowing effects of the development of the embryos. It is also taken into account that these fish may have died 24 hours apart, and therefore may differ in size due to growth period being cut short for some and not others.
Nicotine Exposed, Deceased Specimens
Control Group, Deceased Specimens
EL
3/6/15
The zebrafish groups were attended to again today, In the control group 16/20 had survived, did not swim without stimuli - while 15/20 of the Nicotine group survived and were swimming around without any sort of stimuli. This may indicate nicotine's involvement in behavior due to its stimulating qualities.
CONTROL FISH
NICOTINE FISH
EL
3/1/15
This lab consisted of conducting peer-reviews of the Transect papers. Once the results of the PCR experiment came through with the sequences, they were blasted to identify the bacterial species found within Transect 1.
NNNNNNNNNNNNNNANNNGCAGTCGGANNGGNNGNNNNNNNNNNNNNCGGCNGAGACCGGCGCACGGGTGCGTAACGCGT ATGCAATCTACCTTTTACAGAGGGATAGCCCAGAGAAATTTGGATTAATACCTCATAGTATAACACAATCGCATGATTGA GTTATTAAAGTCACAACGGTAAAAGATGAGCATGCGTCCCATTAGCTAGTTGGTAAGGTAACGGCTTACCAAGGCTACGA TGGGTAGGGGTCCTGAGAGGGAGATCCCCCACACTGGTACTGAGACACGGACCAGACTCCTACGGGAGGCAGCAGTGAGG AATATTGGACAATGGGCGCAAGCCTGATCCAGCCATGCCGCGTGCAGGATGACGGTCCTATGGATTGTAAACTGCTTTTG TACGAGAAGAAACACCTCTTCGTGTAGGGACTTGACGGTATCGTAAGAATAAGGATCGGCTAACTCCGTGCCAGCAGCCG CGGTAATACGGAGGATCCAAGCGTTATCCGGAATCATTGGGTTTAAAGGGTCCGTAGGCGGTTTAGTAAGTCAGTGGTGA AAGCCCATCGCTCAACGGTGGAACGGCCATTGATACTGCTGAACTTGAATTATTAGGAAGTAACTAGAATATGTAGTGTA GCGGTGAAATGCTTAGAGATTACATGGAATACCAATTGCGAAGGCAGGTTACTACTAATGGATTGACGCTGATGGACGAA AGCGTGGGTAGCGAACAGGATTAGATACCCTGGTAGTCCACGCCGTAACGATGGATACTAGCTGTTGGGAGCAATTTCAG TGGCTAAGCGAAAGTGATAAGTATCCCACCTGGGGAGTACGTTCGCAAGAATGAAACTCNNGGAATTGACGGGGGCCCGC ACAAGCGGTGGAGCATGTGGTTTAATTCNATGATACNCGAGGAACCTTACCAANGCTTAAATGTANTGTGNNCCGATNTG GANCAGATCTTTCGCANACAAATTACAANNGCTGCATGGTNGTCNTCAGCTCGTGCCGTGAGNNNCNGNTAANTCCNATA ACGANNCAACCCCTGTNNTTAGTTN
NNNNNNNNNNNGNNNANNCATGCAAGCCGAGCGGTAGAGANCTTTCGGGATCTTGAGAGCGGCGTACGGGTGCGGAACAC GTGTGCAACCTGCCTTTATCAGGGGGATAGCCTTTCGAAAGGAAGATTAATACCCCATAATATATTGAATGGCATCATTT GATATTGAAAACTCCGGTGGATAGAGATGGGCACGCGCAAGATTAGATAGTTGGTAGGGTAACGGCCTACCAAGTCAGTG ATCTTTAGGGGGCCTGAGAGGGTGATCCCCCACACTGGTACTGAGACACGGACCAGACTCCTACGGGAGGCAGCAGTGAG GAATATTGGACAATGGGTGAGAGCCTGATCCAGCCATCCCGCGTGAAGGACGACGGCCCTATGGGTTGTAAACTTCTTTT GTATAGGGATAAACCTTTCCACGTGTGGAAAGCTGAAGGTACTATACGAATAAGCACCGGCTAACTCCGTGCCAGCAGCC GCGGTAATACGGAGGGTGCAAGCGTTATCCGGATTTATTGGGTTTAAAGGGTCCGTAGGCGGATCTGTAAGTCAGTGGTG AAATCTCATAGCTTAACTATGAAACTGCCATTGATACTGCAGGTCTTGAGTAAAGTAGAAGTGGCTGGAATAAGTAGTGT AGCGGTGAAATGCATAGATATTACTTANAACACCAATTGCGAAGGCAGGTCACTATGTTTNANNNNACGCTNATAGGACG AAAGCGTGGGGAGCGAACAGGATTAGATACCCTGGTAGTCCACGCCGTAAACGATGCTAACTCGTTTTTGGGTCTTCGGA TTCAGAGACTAAGCGAAAGTGATAAGTTAGCCACCTGGGGAGTACGTTCGCAAGAATGAAACTCAAAGGAATTGACGGGG GCCCGCACAAGCGGTGGATTATGTGGTTTAATTCGATGATACGCGAGGAACCTTACCAANNCTTAAATGGGAATTGACAG GTTTANAAATANNCTTTTCTTCGNANATTTTCNNNGCTGCATGGNNTCGTCAGCTCNTGCCNTGAGTGTTNGNNAGTCCT GCAACNAGCNCAACCCCTGNCACTANTNGCNNN
The zebrafish were also tended to during this lab. In the control group 17/20 had survived and as before, did not swim without stimuli - while 16/20 of the Nicotine group survived and were swimming around without any sort of stimuli. There were two eggs which had not hatched on day 5 in the nicotine group but did by day 7. This may indicate nicotine's involvement in delayed development.
EL
2/23/15
Embryology & Zebrafish Development
The purpose of this lab was to understand the stages of embryonic development through comparisons between different organisms and to set up the experiment of studying how the environment’s conditions will affect the embryonic development of Zebrafish.
The first three procedures of the lab consisted of comparing the embryonic development of starfish (Asterias), Frogs, and Chicks. With information about the cleavage and gastrulation stages provides for each organism, observations were made and recorded in table 1. These observations, along with the new knowledge of these developmental stages, were compared to human embryonic development.
The next portion of the lab involved preparing for the Zebrafish experiment. Starting with ~18 hour hold fertilized eggs, 20 healthy, translucent embryos were placed into a control dish and another 20 were placed into an experimental dish. With the independent variable in this case being nicotine, 20 mL of water was placed in each dish and the 4 mL of 25mg/mL was placed into only one dish. This administered a dosage of 100 mg of nicotine to the developing embryos. Besides this variable, all others were kept constant between the two dishes – temperature at ~28 degrees C, pH around 7-7.5, and normal day and night light exposure. With this experiment set up, it was hypothesized that the zebrafish exposed to nicotine would display a higher level of movement/ activity pre- and post hatch. To measure movement of the embryos after the administration of the drug, each dish was examined in 10 second intervals, counting and recording the number of movements. This process was repeated 2 days later and then again 5 days later – each time having the nicotine readministered in 100 mg doses. The subsequent days also involved removing 10 mL of the dirty water containing egg shells and dead embryos and adding 25 mLs of clean water. On day 7, a drop of Paramecium was added to each dish as a source of food. The observations made on day 5 were recorded in table 2.
EL
2/17/15 Invertebrates
The purpose of this lab was to comprehend the importance of invertebrates and how simple systems evolved into ones much more complex. The first procedure consisted of observing and comparing the structure and movement of Acoelomates, Pseudocoelomates, and Coelomates. The Acoelomates were long and very flat and moved side to side in a forward motion. The Pseudocoelomates were shaped differently, found to be more long and circular in cross-section, making it much easier to move in a spiral-motion. The Coelomates however moved in a more hydrolic motion, and was ovular in cross-section.
Many different types of invertebrates similar and not to these were found in the Burlese funnel sample taken from Transect 1. Last week the Berlese funnel was set up to collect invertebrates. After setting up the funnel by securing it in an air-tight manner to the flask below, 25 mL of 50:50 ehtanol/water solution was poured into the conical tube. The funnel was set up on a ring stand and the leaves were slowly but firmly packed into the funnel. A 40 watt bulb was placed above the funnel about 1-2 inches from the top of the leaves, and then covered with foil to wait for a week.
With the funnel attached securely and sealed to the tube below containing the ethanol solution, the seal was carefully removed and the leaf litter was discarded from the funnel. The sample collected in the tube below was split into two observable dishes. One contained ~10-15 mL of sample from the top of the tube, and another from the bottom, as organism of different sizes separated out into layers within the solution. Five different invertebrates were selected from the samples for analysis and measured using the microscopes ocular micrometer. All observations were collected in the table below. A large amount of ground spiders were found in the sample, along with springtails (primitive insects).
Soil mites and proturans were also present, along with a few deer ticks and other invertebrates that were not chosen to be examined. It was considered that the presence of these organisms within this transect is due to their need for water access during cold, dry months. The presence of some of the invertebrates, such as the deer ticks and mites may be permanent residents, or likely to have been carried in by outside organisms, such as deer or squirrels that come into the boundaries of the transect. Within such a moist environment like this marsh, many of the invertebrates are able to help take part in the decomposition processes of the organic matter. This allows for the death of some organisms to help fuel the sustainability of others – keeping Transect 1 an ecosystem in itself. Photos of some of the collected organisms has been provided below.
EL
2/9/15
Lab 4: Plantae & Fungi
The purpose of this lab was to understand the diverse characteristics of plants as well as explore the importance of fungi and its functions. In the first procedure, two Ziploc bags were taken to Transect 1: one for a large 500 gram collection of leaf litter and one for obtaining 5 different plant species present. The leaves were later placed in a Berlese funnel for the later collection of invertebrates. Each plant was marked with a number, 1 -5, and their locations were marked on a representative four quadrant grid below.
Plant number one has tall long, narrow leaf shoots, with thick soft casings along the top, which are brown around the outside and white in the middle– commonly referred to as cattails. These soft fluffy pieces that can be pulled from this casing are very light weight can easily be carried by the wind – likely the method of pollination for the plant. From the wetland environment of transect 1, this plant likely falls in the Typha genus. Plant two was along the ground, under coverage of other plants, mossy and dark green, and very integrated into the soil. This plant shows only horizontal growth, but no vertical growth – likely a bryophyte. Plant three, standing about 3.5 ft tall consists of long thin branches which are alive and green on the inside with a brown dusty coating on the outside. Small red berries were also found on this plant (which was kindly labeled for us as a “red cardinal flower bush” – a member of the lobelia genus). Plant four was taller and also bush-like, standing at about 5.5 ft tall. Consisting of very thin, long branches, the plant carries small, dried, brown pod-like structures which when cracked open reveal a seed-like feature. Plant five stood around 4 ft tall with long, thin, dark-red branches that have small flower-like structures on the tips. Both plants 4 and 5 may be considered angiosperms.
Procedure two consisted of comparing the moss, Mnium with the Angiosperm, lily. The height of the moss plant was observed to be considerably less than that of the lily plant’s stem. The cross section of the lily stem was also examined to find the xylem and phloem structures. The vascularization of each plant from the transect was also examined. Plant 1’s stem was the tallest of the transect plants, and the cross section revealed a hollow, light brown shoot. Due to the time of year, only the branches of the bush plants were available to be examined, so the cross-section of plant 2 did not reveal any observable detail under the microscope, besides ill-defined rings which radiated out from the center of the cross-section. This was also the case for plants 4 and 5, but plant 5 became a slightly lighter shade of red towards the center of its branch. Plant two, being a moss, showed very similar features to those seen on the Mnium earlier. The descriptive chart has been provided below:
Samples of fungi were all observed, focusing on the importance of sporangia. Creating the spores needed for reproduction, sporangia are important to the succession of plants. The mushrooms examined, with such sophisticated structures, fall into the basidiomycota group and the black bread mold would likely be apart of the Ascomycota group. Lastly the Berlese funnel was set up to collect invertebrates. After setting up the funnel by securing it in an air-tight manner to the flask below, 25 mL of 50:50 ehtanol/water solution was poured into the conical tube. The funnel was set up on a ring stand and the leaves were slowly but firmly packed into the funnel. A 40 watt bulb was placed above the funnel about 1-2 inches from the top of the leaves, and then covered with foil to wait for a week.
-EL
2/2/15 Microbiology and Identifying Bacteria with DNA Sequences
The purpose of this lab was to learn about traits of bacteria, observe them in the presence of antibiotics to understand resistance, and learn how to identify species using DNA sequencing via PCR. Once learning about the extreme conditions under which Archaea live, which are very unlike those of Transect 1 and the agar plate, it seems unlikely that any will have grown here. If these plates were kept in more extreme environments, such as in ice, heat, or high pressures, it may be more possible for Archaea to thrive.
Before beginning the procedures of this lab, a hypothesis was made on how the Hay Infusion Culture changed since the previous week. It was hypothesized that the appearance and smell of the culture would be different than last week due to the fluctuations in population sizes of all the present organisms – some fungi may be more present than it was last week, etc. It was then observed that it was much darker, more mold was present, water had evaporated, it smelled more like rotten eggs this week, a lot of paste-like residue was lining the sides of the jar, and cloudy auras encapsulated floating objects, like grass blades.
This lab involved observing the growth of the nutrient and tetracycline agar plates that were inoculated from the infusion cultures. The numbers of each colony were carefully counted and recorded in the table below. One observation made was that all tetracycline plates harbored a large amount of fungal growth but less bacterial growth, indicating the presence of antibiotic-resistant bacteria present in the culture. Approximately 3-4 species of bacteria seemed to be unaffected by the antibiotics, while the rest that flourished on the non-tet plates. When the tetracycline targets the peptidoglycan of the bacteria’s cell walls, the bacteria not carrying the resistant-mutation do not survive to reproduce.
When observing the bacterial cell morphology, the use of 100X oil immersion was first familiarized before any observations were made. Four wet mounts were prepared for observation, 2 from the nutrient agar plates, and 2 from the nutrient agar plates with tetracycline (10-7 and 10-9 of each). Under 100X oil immersion, the nutrient agar 10-7 colony displayed hues of orange and blue, clumped into colonies about 20 µm in diameter, and seemingly immobile. Those on the nutrient agar 10-9 plate were dark purple in color, long/ string-like, and also seemingly immobile. When observing the antibiotic agar plates, the 10-7 colony was approximately 25 µm in diameter and appeared semi-transparent, similar to a clump of hair in appearance, while the 10-9 tet-plate did not fully focus, the colony showed long, string-like strips that formed clusters.
Gram Stain Materials and Methods – When beginning this process, a sample of growth was collected from the each agar plate after sterilizing the loop over a Bunsen burner. The slides were labeled 10-7, 10-9, Tet 10-7 , and Tet 10-9. The slides were taken to the staining trays and the smears were covered with crystal violet for a minute, and then rinsed with water. The smear was the covered with iodine mordant for another minute and rinsed with water. To remove the color, the smear was flooded with 95% alcohol for 10-20 seconds, and then rinsed again. The smear is the covered again but this time with safranin for 25 seconds, rinsed with water, and blotted with a kimwipe. Each sample is observed under 40X and 100X oil immersion and all data was recorded in the table below – pictures were taken of each sample instead of drawing to preserve accuracy.
To set up for the PCR 16s sequencing, a single colony of bacteria was transferred into 100 µL of water in a sterile tube. After incubating for 10 minutes in a 100oC heat block, the samples were centrifuged for 5 minutes at 13,400 rpm. Meanwhile, 20 µL of primer/water mixture was added to labeled PCR tube and mixed in order to dissolve the PCR bead inside. 5 µL of the supernatant from the centrifuged samples were transferred to the 16S PCR reaction, and placed in the PCR machine. Next week the samples will be examined to identity the bacteria.
1/21/15 I love protists!
Very complete! Great job! Keep it up! ML
1/22/15 Identifying Algae & Protists The purpose of this lab was to become familiar with the use of a dichotomous key to identify organisms and in doing so, examine the different characteristics displayed by various algae and protists from Transect 1.
Methods The first procedure focused on learning how to accurately use the dichotomous key to identify known organisms on a wet mount under the microscope. Once comfortable with this skill, the dichotomous key was used to identify unknown organisms under the 4X and 10X objectives. The second procedure involved making wet mounts of samples from the hay infusion culture obtained the week previous. After noting all observations of these samples, the dichotomous key was again used to identify as many present organisms as possible. The third procedure required prepping and plating serial dilutions of samples from the hay infusion culture, once it had been swirled (allowing the settled niches of the organisms to blend). 100 mL tubes of sterile broth were labeled and 100 microliters of the hay infusion culture was micropippeted into the first tube and shaken. 100 microliters was transferred from tube 1 to tube 2 in similar fashion until all four tubes are ready (see diagram below for reference).
Agar plates were subsequently labeled and 100 microliters from each tube was transferred to each plate - this process was repeated for the plates containing antibiotic tetracycline. All samples were spread evenly across the plates in a sterile manner to avoid contamination and error. The plates were then set aside to incubate and room temperature for lab 3.
Data, Observations, & Findings Procedure I -unknown organism found under microscope was approximately 20 micrometers in length -colorless, swimming quickly with cilia, maintained an ovular body shape -> narrowed down to be colpidium sp
Procedure II: Hay Infusion Culture of Transect 1 sample presented a sour, foul odor, with a green, cloudy marsh-like appearance that had a thin solidified layer on top. After investigating more closely the nature of these organisms, Didinium for example, it can be observed that this life fulfills all necessary criteria for being alive: -It is made of cells, it has different levels of organization within it (note image drawn below) -It uses energy (in this case, likely the milk powder provided previously) -It responds to things in its environment (became slowed when in coming into contact with the paralytic agent) -It reproduces (which is apparent due to the vast number of individuals found within this sample - likely more to be found next lab) -It adapts to its environment (although this cannot be observed directly, this organism is displaying all signs of life even after being removed from its original environment of the transect to this culture sample)
Conclusions Two organisms found in the sample are a part of the Volvocine Line, as the chlamydomonas and volvox identified can be found in environments with characteristics similar to those of Transect 1. If this culture continues to flourish for another couple months, each population of organisms will likely compete with one another for space. The carrying capacity of this small jar is limited, so the fungi, bacteria, and protists present will both continue to coexist but not all individuals will survive due to the conditional limitations of this environment.
-ERL
1/26/15 Lab 1: Biological Life at AU
Good job! You have all the necessary information, but more pictures and more information may help you help you when you are compiling all this at the end of the project. ML
The purpose of this lab was to understand the role of natural selection in evolution by observing the traits of organisms that are members of the Volvocine Line under the microscope, as well as observe and record observations of a niche.
Methods In the first half of the experiment living slides of Chlamydomonas, Gonium, and Volvox were examined and observations were recorded in the table below. The mechanisms for motility, ways of reproduction, and colony size were all noted. The second part of the experiment consisted of visiting the assigned Transect on campus to develop our observational skills. A sample was collected in a 50 mL conical tube for a hay infusion culture to be made subsequently, and everything that went into this sample was recorded for later use. Once back to the lab, the culture was made by placing 10 grams of the sample into a large plastic jar along with 500 mLs of deerpark water. 1 gram of dried milk was added to provide food to any living organisms in the sample that may need it. The culture was gently mixed and the jar was left open in the lab for a week, after being labeled “Transect 1”.
Data, Observations & Conclusions All Data collected for the first half of the lab has been recorded in the table below:
Transect 1 considered to be the “Marsh” was full of life, even during the cold season. It is located close to Massachusetts Avenue, containing a drain, where any run-off can go. The ground was relatively soft and wet, due to recent snow-fall, but not yet fully frozen. Both biotic and abiotic components found within the transect were recorded in the table below. A photo of transect 1 has also been provided below. It is likely that once the culture incubates for a week, there will be a wide range of organisms to be found from Transect 1.
ERL